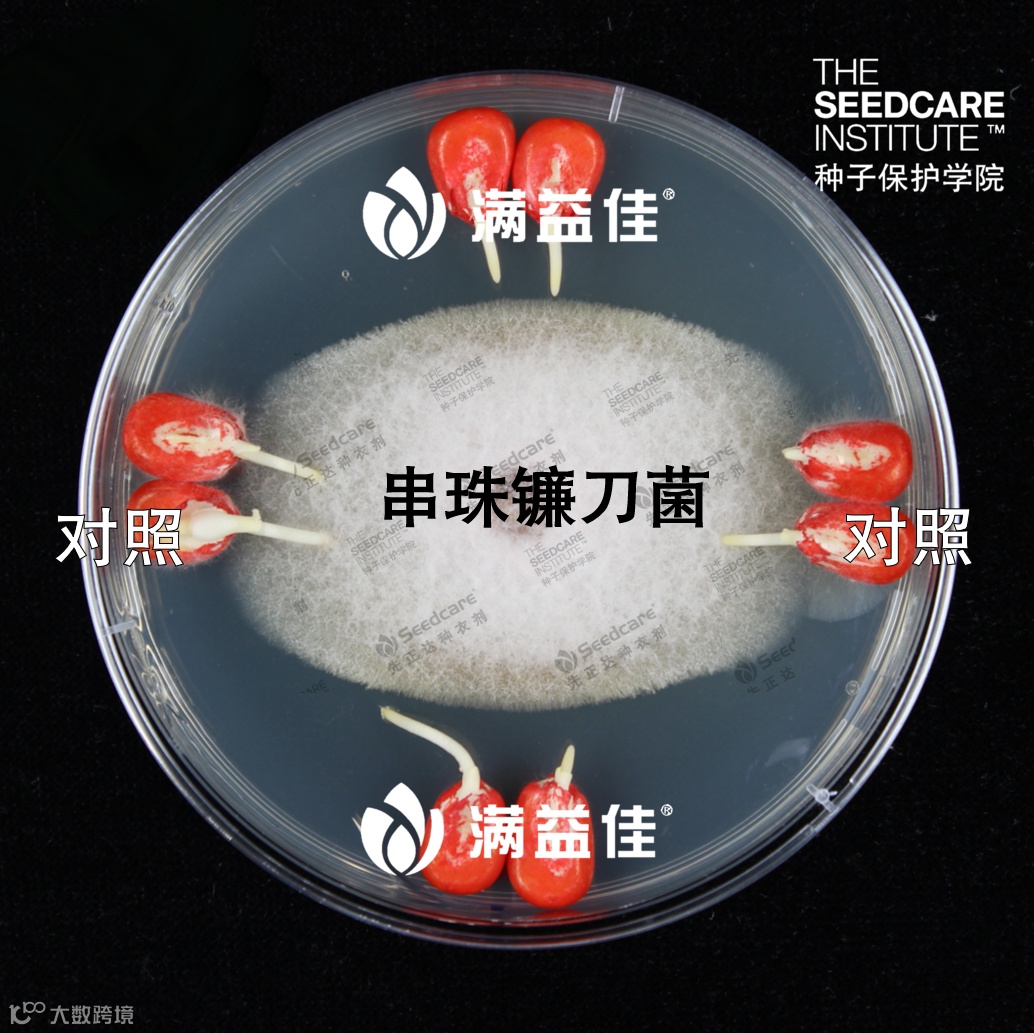

4月2日,先正达集团中国宣布成立“种业共创平台”( Seeds Technology Solution,以下简称“STS平台”)。该平台将利用先正达集团所拥有的种子生物育种技术、遗传育种技术、分子标记辅助育种技术、基因编辑技术、种子生产技术,以及植保方面的技术产品,为中国的种子企业以及种植者提供定制化或集成化解决方案。平台在凭借丰富经验来赋能中国种子企业,满足农民对种植投入需求的同时,努力为打赢种业翻身仗做出卓越贡献。
“先正达集团中国是‘打赢种业翻身仗’的核心力量,STS平台的成立,是这场‘战役’的重要里程碑。”先正达集团中国总裁覃衡德在STS平台成立活动现场如是说,“打赢种业翻身仗对中国的粮食安全极其重要,而最终对全世界都具有重要影响。在这一历史时刻,先正达集团中国必须要有担当。我们希望把拥有的技术、能力、人才、资源结合在一起,以利他、共荣、共赢的理念,打造一个为用户和合作伙伴赋能的创新平台,用科技的力量和创新的商业模式,把拥有的知识、经验、多元化的产品组合和服务,更好地传递给合作伙伴,为中国的农户提供更好的服务,为中国种业公司的可持续发展和繁荣,贡献知识、经验、能力和产品。在先正达集团中国拥有的为种业企业赋能的综合能力里,我们的MAP平台将来也会并且正在为种业企业赋能,一是打通种业与消费端的价值链条,二是将来可以用消费者的品质需求大数据来指导精准育种等。”

🔼先正达集团中国总裁覃衡德在STS平台成立活动上发言
先正达集团中国副总裁、种子业务总裁汪泓对STS平台的未来发展充满信心。他表示:
据了解,基于先正达集团中国旗下MAP平台和广泛的业务渠道优势,STS平台将从消费端需求切入,深入了解种植者对种子产品及技术的需求。在此基础上,充分利用先正达集团在全球范围内的资源和渠道,寻找适用的领先技术,并结合国内科研院校的可商业化技术,为种植户、经销商和种子企业提供多样化、定制化和集成化的技术解决方案。
🔼可视化展示种衣剂产品对靶标病原菌的抑制作用
和对种子的预防保护
先正达集团中国玉米业务总经理刘瑞丰在活动现场也介绍了STS平台的团队:

🔼STS平台团队为合作伙伴进行种子包衣应用技术培训
据悉,STS平台在成立初期的工作将聚焦玉米业务,今后逐步拓展到其它种子作物。STS平台计划通过合作伙伴访谈、技术储备盘点和可商业化技术产品合作等方式,透彻了解供应端和需求端的需求及痛点,明确解决方案的构成要素,并与潜在用户探讨合作内容和模式。



